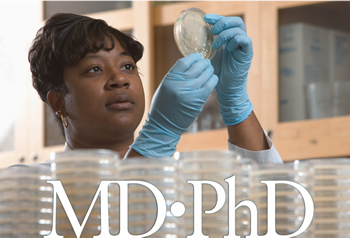

çoçuk Doktoru Olmak Için Kaç Puan Gerekir

Doktor Olmak Icin Kac Yil Okumak Gerekiyor Doktor Bun

Kalp Cerrahi Olmak Icin Kac Puan Gerekir

Doktor Nasil Olunur Doktor Olmak Hakkinda Tum Detaylar

Cocuk Doktoru Nasil Olunur Pediatrist Olmak Doktor Bun

Tip Fakultesi Kazanmak Icin Kac Puan Almak Gerekir Doktor Bun

Kalp Cerrahi Olmak Icin Kac Puan Gerekir

Tus 2018 Degerlendirme Raporu En Yuksek Puan Yine Dermatoloji De Medimagazin Saglik Haber Portali Saglik Personeli Haberleri

Tip Okuyanlarin Sikca Karsilastigi 15 Soru Ve Durum Onedio Com

Doktor Olmak Icin Hangi Okula Gitmeliyim E Okul Veli Ogrenci Giris

Tus 2018 Degerlendirme Raporu En Yuksek Puan Yine Dermatoloji De Medimagazin Saglik Haber Portali Saglik Personeli Haberleri

Doktor Olmak Icin Hangi Okullari Okumak Gerekir Doktor Bun

Hemsirelik Kazanmak Icin 2020 Yks De Kac Net Gerekir

Cocuk Doktoru Nasil Olunur Pediatrist Olmak Doktor Bun

Cocuk Doktoru Olmak Icin Gerekli Asamalar Nelerdir

Doktor Nasil Olunur Doktor Olmak Icin Ne Yapilmalidir Son Dakika Haberler

Kac Puanla Hangi Universite Bolumune Yerlesilir 190 200 250 Ve 300 Puanla Gidilecek Bolumler Egitim Haberleri

Nasil Doktor Olunur Doktor Olmak Icin Yapilmasi Gerekenler Nedir

Tip Fakultesi Kazanmak Icin Kac Net Yapmak Gerekir Webders Net

Doktor Olabilmek Icin En Az Kac Puan Gerekir E Okul Meb

Tus Ta Tercih Siralamasi Nasil Degisti En Cok Puan Alanlar Hangi Branslari Tercih Ediyor Medimagazin Saglik Haber Portali Saglik Personeli Haberleri

Kalp Cerrahi Olmak Icin Kac Puan Gerekir

Profesor Nedir Nasil Olunur Profesor Doktor Olmak Icin Kac Yil Gerekir Kariyer Haberleri

Doktor Nasil Olunur Maaslari Ne Kadar 2021 Is Fikirleri

Tip Fakultesi Egitimi Tip Okumak Kac Yildir Tip Kac Yil Sene Doktor Bun

Hemsire Olabilmek Icin Kpss Den Kac Puan Almak Gerekiyor 2021 Hemsire Alim Puanlari Egitim Haberleri

Tip Okuyanlarin Sikca Karsilastigi 15 Soru Ve Durum Onedio Com

Doktor Olmak Icin Hangi Derslerin Iyi Olmasi Gerekir Not Bu

Iste Tus Ta Yuksek Puan Alan Doktorlarin Tercih Ettigi Uzmanlik Branslari Memurlar Net

Kalp Cerrahi Olmak Icin Kac Puan Gerekir

Tip Icin Kac Net Gerekli 2018 Yks Gercek Sonuclar Youtube

Tip Okuyanlarin Sikca Karsilastigi 15 Soru Ve Durum Onedio Com

Doktor Nasil Olunur Maaslari Ne Kadar 2021 Is Fikirleri

Kac Puanla Hangi Universite Bolumune Yerlesilir 190 200 250 Ve 300 Puanla Gidilecek Bolumler Egitim Haberleri

Nasil Cerrah Olunur Cerrahlik Bolumleri Nelerdir Doktor Bun

Zabita Alim Puanlari 2021 Zabita Olmak Icin Kpss Den Kac Puan Almak Gerekiyor Egitim Haberleri

Tip Fakultesi Kazanmak Icin Ilk Kac Bine Girmek Gerekiyor 2019 2020

Dhmi Memuru Olmak Icin Kac Puan Almak Gerekir Dhmi Ne Demektir Kpss Rehber

Tip Fakultesi Kazanmak Icin Nasil Calisilmali Sinavhanem

Bekci Olabilmek Icin Kpss Ortaogretim Sinavindan Kac Puan Almak Gerekiyor Bekci Alim Puanlari Egitim Haberleri

Dis Hekimi Olmak Icin Kac Yil Okumak Gerekiyor Doktor Bun

Tip Fakultesi Taban Puanlari Basari Siralamasi 2020 Tip Fakultesi Kac Puan Tip Fakultesi Puanlari Takvim

Tip Okuyanlarin Sikca Karsilastigi 15 Soru Ve Durum Onedio Com

Polis Alimi Pmyo Pomem Icin Kpss Ortaogretim Sinavindan Kac Puan Almak Gerekir Egitim Haberleri

2020 Lgs Sinavi Puan Hesaplamasi Bu Sinavda Kac Net Kac Puan Yapar Egitim Haberleri

Cocuk Doktoru Nasil Olunur Cocuk Psikiyatri Doktoru Olma Sartlari Kariyer Haberleri

Cocuk Doktoru Olmak Icin Hangi Derslerin Iyi Olmasi Gerekir Tercihrehberin Com

Doktor Olmak Icin Hangi Liseye Gitmeliyim

Tip Okuyanlarin Sikca Karsilastigi 15 Soru Ve Durum Onedio Com

Tus Ta Tercih Siralamasi Nasil Degisti En Cok Puan Alanlar Hangi Branslari Tercih Ediyor Medimagazin Saglik Haber Portali Saglik Personeli Haberleri

Lgs 50 60 70 Net Kac Puan Lgs Taban Puan Hesaplama Istanbul Fen Anadolu Liseleri Taban Puanlari Takvim

Anestezi Doktoru Nedir Nasil Olunur Anestezi Doktorlugu Mezunu Ne Is Yapar Kariyer Haberleri

Psikoloji 2020 Taban Puanlari Ve Siralamasi Unirehberi

Psikoloji Icin Kac Net Kac Puan Gerek Gercek Sonuclar

Ogrenciler Universitelerden Ne Kadar Memnun Ntv

2020 Iokbs Bursluluk Sinavi Kac Puanla Kazanilir 2020 Meb Bursluluk Sinavi Tavan Ve Taban Puanlari Nedir

Cocuk Alerji Doktoru Nasil Olunur Prof Dr Ahmet Akcay

Tip Fakultesi Icin Kac Net Gerekir 2018 Tip Icin Kac Puan Lazim

2020 Yks Sayisal Puan Turunde 170 Puani Gecmesi Icin Kac Net Yapmak Gerekir Tyt De 200 250 300 Puan Nasil Alinir Takvim

Basarili Bir Doktor Olmak Icin Olmazsa Olmaz 10 Sey Dsn Doktorlarsitesi Net

Belediyeye Kpss 60 Puan Ile Zabita Memuru Alimi Basladi Guncel Haberleri

Doktor Maaslari 2020 Ne Kadar

Doktor Nasil Olunur Maaslari Ne Kadar 2021 Is Fikirleri

Sadece Sinav Degil Okul Basariniz Da Onemli Egitim Haberleri

Bursluluk Kac Puanla Kazanilir 5 6 7 8 9 10 11 Sinif Bursluluk Taban Puani Kac 2020 Iokbs Puan Hesaplama Takvim

Tip Fakultesi Icin Kac Net Gerekir 2021 Tip Netleri Unirehberi

Pybs Bursluluk Sinavi Kac Puanla Kazanilir 2019

Kalp Cerrahi Olmak Icin Kac Puan Gerekir

Tsalatsatul Ushul Sesi 2 Masjid Amwa

Cocuk Doktoru Nasil Olunur Pediatrist Olmak Doktor Bun

Cocuk Doktoru Nasil Olunur Cocuk Doktoru Maaslari Ne Kadar

Dis Hekimligi Okumak Dis Hekimligi Egitimi Hakkinda Her Sey

Kalp Cerrahi Olmak Icin Kac Puan Gerekir

Ogrenciler Universitelerden Ne Kadar Memnun Ntv

Hemsirelik Okumak Icin Universite Sinavinda Kac Net Almak Gerekiyor Egitim Haberleri

Aile Hekimi Kimdir Nasil Olunur Olma Sartlari Nelerdir

Cocuk Doktoru Secerken Nelere Dikkat Ettim Tanla Bilir

Tus Nedir Nasil Hazirlanmak Gerekir Neler Cikar Konusarak Ogren

Dis Hekimligi Kazanmak Icin 2020 Yks De Kac Net Gerekir

Algernon A Cicekler Keyes Daniel Download

Kpss Ortaogretim Lise Kac Puanla Nereye Basvurulur Kpss Ortaogretim Lise 50 60 70 Puanla Memur Alimi Yapan Kurumlar Takvim

Cerrah Nasil Olunur Ne Kadar Maas Alir

Neden Doktor Olmak Istiyorum Universkop Com

Chapter Five English Books

Dis Hekimligi Taban Puan Siralamasi Hangi Universitede Dis Hekimligi Kac Puan Gundem Haberleri

Onlisans 55 56 57 58 59 Kpss Ile Memur Alimi Yapan Yerler Kpss 55 56 57 58 59 Puanla Nereye Girilir Takvim

Takdir Tesekkur Icin Kac Puan Lazim E Okul Takdir Tesekkur Hesaplama 2019 Ogrenciler Belge Aliyor

Polis Alimi Pmyo Pomem Icin Kpss Ortaogretim Sinavindan Kac Puan Almak Gerekir Egitim Haberleri

Hemsirelik Taban Puanlari Hemsirelik Bolumu Puanlari Hemsirelik Icin Kac Net

Doktor Nasil Olunur Nasilolunur Net Nasil Olunur Bilen Adres

Tip Fakultesi Kazanmak Icin Kac Net Yapmak Gerekir Doktor Bun

Osym Msu 2020 Astsubay Subay Taban Tavan Puanlari Kac 2020 Msu Sinavi Kazanmak Icin Kac Net Yapmak Gerekir Takvim

Zhjkig1w1ihyym

2020 Iokbs Bursluluk Sinavi Kac Puanla Kazanilir 2020 Meb Bursluluk Sinavi Tavan Ve Taban Puanlari Nedir

Hukuk Kazanmak Icin Kac Bine Girmek Gerekir

Hemsirelik Icin Kac Net Kac Puan Gerekli Gercek Sonuclar Youtube

Almanya Da Hemsirelik Deneyimi Otantik Bakim

Pmyo Taban Puanlari Ve Aktif Pmyo Sayisi Kac
Md Phd Turkiye Tipta Doktora Imkanlarina Giris

Doktor Nasil Olunur Maaslari Ne Kadar 2021 Is Fikirleri